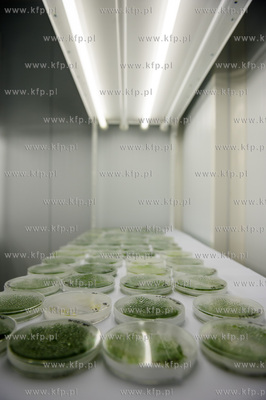
Gdansk. Otwarcie Instytutu Biotechnologii Uniwersytetu...

AGENCJA FOTOGRAFICZNA
Pierwsze zajęcia w nowym budynku Instytutu Biotechnologii Uniwersytetu Gdańskiego ruszyły przed dwoma miesiącami, wraz z początkiem semestru letniego. Uroczyste otwarcie jednego z najnowocześniejszych obiektów naukowo-dydaktycznych w Polsce odbyło się w czwartkowe przedpołudnie. Przeprowadzka Instytutu z dotychczasowej siedziby Międzyuczelnianego Wydziału Biotechnologii UG i GUMed. na ul. Kładki 24 do gmachu na ul. Abrahama 58 w 90 proc. stała się faktem. – Nowy obiekt wpisuje się w wieloletni plan inwestycyjny uczelni na lata 2011-2020, zakładający koncentrację budynków UG w trzech kampusach - sopockim, gdyńskim i gdańskim. Przeniesienie kolejnego wydziału eksperymentalnego UG na teren kampusu w Oliwie znacznie przyczyni się do realizacji idei interdyscyplinarnych badań naukowych i procesu dydaktycznego. W większym zakresie możliwe będzie realizowanie wspólnych projektów naukowych i dydaktycznych – mówi prof. dr hab. Bernard Lammek, rektor UG.
Budowa IB rozpoczęła się w 2014 roku, a zakończyła w grudniu 2015 roku. Całkowita wartość inwestycji wynosi ponad 60,5 miliona zł. Niemal w całości została on zrealizowana za pieniądze z Programu Operacyjnego Infrastruktura i Środowisko. Projekt budynku powstał w Warsztacie Architektury Pracowni Autorskiej Krzysztof Kozłowski w Sopocie. Wykonawcą inwestycji było Konsorcjum Block. Budynek o powierzchni użytkowej ok. 8 tys. metrów kwadratowych ma pięć kondygnacji. W obiekcie znajdują się laboratoria specjalistyczne, m.in. bioinformatyczne, analiz biomolekularnych, zespół fitotronów, laboratorium o podwyższonych wymaganiach czystości i szczelności, laboratorium izotopowe, pracownie do badań rozwojowych oraz nowoczesne pomieszczenia dydaktyczne dla studentów i doktorantów, w tym sale seminaryjne, sale komputerowe, audytorium na 200 osób z możliwością podziału na dwa mniejsze, pomieszczenie dla kół studenckich, czytelnia i sala Rady Wydziału. W specjalistycznym laboratorium bioinformatycznym zostanie utworzony tzw. klaster obliczeniowy (zespół specjalistycznych komputerów), z którego będą korzystali pracownicy naukowo-dydaktyczni oraz studenci i doktoranci. Budynek został podzielony na trzy funkcjonalne strefy: ogólnodostępną (część dydaktyczna, laboratoria dydaktyczne, część biurowa i socjalna), zamkniętą (laboratoria naukowo -badawcze, specjalistyczne, pomieszczenia pomocnicze, biura naukowe), oraz techniczną i socjalną.
Międzyuczelniany Wydział Biotechnologii Uniwersytetu Gdańskiego i Gdańskiego Uniwersytetu Medycznego jest wiodącą instytucją naukowo-dydaktyczną w Polsce. Działania unikatowej w skali kraju jednostki znamionuje interdyscyplinarny charakter badań naukowych i dydaktyki łączących zagadnienia biomedyczne, biomolekularne i ich zastosowania w biotechnologii dla zdrowia i poprawy jakości życia. Wydział otrzymał wyróżniającą ocenę jakości kształcenia nadawaną najwybitniejszym jednostkom w kraju przez Polską Komisję Akredytacyjną. Ministerstwo Nauki i Szkolnictwa Wyższego przyznało biotechnologii tytuł Najlepszego Kierunku Studiów. Absolwenci wydziału zatrudniani są w czołowych ośrodkach naukowych w kraju i za granicą (Karolinska Institut, Harvard University, Cambridge, Royal College, MIBMiK, Instytuty PAN) oraz przedsiębiorstwach z branży life-science (Procter & Gamble, Novartis, Crucell, Polpharma). 14.04.2016 / fot. Mateusz Ochocki / KFP
Budowa IB rozpoczęła się w 2014 roku, a zakończyła w grudniu 2015 roku. Całkowita wartość inwestycji wynosi ponad 60,5 miliona zł. Niemal w całości została on zrealizowana za pieniądze z Programu Operacyjnego Infrastruktura i Środowisko. Projekt budynku powstał w Warsztacie Architektury Pracowni Autorskiej Krzysztof Kozłowski w Sopocie. Wykonawcą inwestycji było Konsorcjum Block. Budynek o powierzchni użytkowej ok. 8 tys. metrów kwadratowych ma pięć kondygnacji. W obiekcie znajdują się laboratoria specjalistyczne, m.in. bioinformatyczne, analiz biomolekularnych, zespół fitotronów, laboratorium o podwyższonych wymaganiach czystości i szczelności, laboratorium izotopowe, pracownie do badań rozwojowych oraz nowoczesne pomieszczenia dydaktyczne dla studentów i doktorantów, w tym sale seminaryjne, sale komputerowe, audytorium na 200 osób z możliwością podziału na dwa mniejsze, pomieszczenie dla kół studenckich, czytelnia i sala Rady Wydziału. W specjalistycznym laboratorium bioinformatycznym zostanie utworzony tzw. klaster obliczeniowy (zespół specjalistycznych komputerów), z którego będą korzystali pracownicy naukowo-dydaktyczni oraz studenci i doktoranci. Budynek został podzielony na trzy funkcjonalne strefy: ogólnodostępną (część dydaktyczna, laboratoria dydaktyczne, część biurowa i socjalna), zamkniętą (laboratoria naukowo -badawcze, specjalistyczne, pomieszczenia pomocnicze, biura naukowe), oraz techniczną i socjalną.
Międzyuczelniany Wydział Biotechnologii Uniwersytetu Gdańskiego i Gdańskiego Uniwersytetu Medycznego jest wiodącą instytucją naukowo-dydaktyczną w Polsce. Działania unikatowej w skali kraju jednostki znamionuje interdyscyplinarny charakter badań naukowych i dydaktyki łączących zagadnienia biomedyczne, biomolekularne i ich zastosowania w biotechnologii dla zdrowia i poprawy jakości życia. Wydział otrzymał wyróżniającą ocenę jakości kształcenia nadawaną najwybitniejszym jednostkom w kraju przez Polską Komisję Akredytacyjną. Ministerstwo Nauki i Szkolnictwa Wyższego przyznało biotechnologii tytuł Najlepszego Kierunku Studiów. Absolwenci wydziału zatrudniani są w czołowych ośrodkach naukowych w kraju i za granicą (Karolinska Institut, Harvard University, Cambridge, Royal College, MIBMiK, Instytuty PAN) oraz przedsiębiorstwach z branży life-science (Procter & Gamble, Novartis, Crucell, Polpharma). 14.04.2016 / fot. Mateusz Ochocki / KFP
dodaj do koszyka wszystkie wyświetlone zdjęcia
- znalezionych zdjęć: 53
- < poprzednia
- strona:
- 1
- 2
- [3]
- 4
- następna >

t00057079.jpg (2832px x 4256px) 2882kb
Gdansk. Otwarcie Instytutu Biotechnologii Uniwersytetu Gdanskiego.
14.04.2016
fot. Mateusz Ochocki / KFP

t00057080.jpg (3725px x 2479px) 1965kb
Gdansk. Otwarcie Instytutu Biotechnologii Uniwersytetu Gdanskiego.
14.04.2016
fot. Mateusz Ochocki / KFP

t00057081.jpg (2832px x 4256px) 3708kb
Gdansk. Otwarcie Instytutu Biotechnologii Uniwersytetu Gdanskiego.
14.04.2016
fot. Mateusz Ochocki / KFP

t00057082.jpg (4256px x 2832px) 3210kb
Gdansk. Otwarcie Instytutu Biotechnologii Uniwersytetu Gdanskiego.
14.04.2016
fot. Mateusz Ochocki / KFP
t00057083.jpg (2670px x 4012px) 1555kb
Gdansk. Otwarcie Instytutu Biotechnologii Uniwersytetu Gdanskiego.
14.04.2016
fot. Mateusz Ochocki / KFP

t00057084.jpg (3767px x 2507px) 1819kb
Gdansk. Otwarcie Instytutu Biotechnologii Uniwersytetu Gdanskiego.
14.04.2016
fot. Mateusz Ochocki / KFP

t00057085.jpg (4256px x 2832px) 1980kb
Gdansk. Otwarcie Instytutu Biotechnologii Uniwersytetu Gdanskiego.
14.04.2016
fot. Mateusz Ochocki / KFP

t00057086.jpg (2427px x 3647px) 1211kb
Gdansk. Otwarcie Instytutu Biotechnologii Uniwersytetu Gdanskiego.
14.04.2016
fot. Mateusz Ochocki / KFP

t00057087.jpg (2991px x 1990px) 758kb
Gdansk. Otwarcie Instytutu Biotechnologii Uniwersytetu Gdanskiego.
14.04.2016
fot. Mateusz Ochocki / KFP

t00057088.jpg (3640px x 2422px) 1760kb
Gdansk. Otwarcie Instytutu Biotechnologii Uniwersytetu Gdanskiego.
14.04.2016
fot. Mateusz Ochocki / KFP

t00057089.jpg (4256px x 2832px) 3068kb
Gdansk. Otwarcie Instytutu Biotechnologii Uniwersytetu Gdanskiego.
14.04.2016
fot. Mateusz Ochocki / KFP

t00057090.jpg (4256px x 2832px) 3138kb
Gdansk. Otwarcie Instytutu Biotechnologii Uniwersytetu Gdanskiego.
14.04.2016
fot. Mateusz Ochocki / KFP

t00057091.jpg (3979px x 2648px) 2605kb
Gdansk. Otwarcie Instytutu Biotechnologii Uniwersytetu Gdanskiego.
14.04.2016
fot. Mateusz Ochocki / KFP

t00057092.jpg (3817px x 2540px) 2275kb
Gdansk. Otwarcie Instytutu Biotechnologii Uniwersytetu Gdanskiego.
14.04.2016
fot. Mateusz Ochocki / KFP

t00057093.jpg (4176px x 2779px) 3013kb
Gdansk. Otwarcie Instytutu Biotechnologii Uniwersytetu Gdanskiego.
14.04.2016
fot. Mateusz Ochocki / KFP

t00057094.jpg (4125px x 2745px) 2710kb
Gdansk. Otwarcie Instytutu Biotechnologii Uniwersytetu Gdanskiego.
14.04.2016
fot. Mateusz Ochocki / KFP
- znalezionych zdjęć: 53
- < poprzednia
- strona:
- 1
- 2
- [3]
- 4
- następna >





